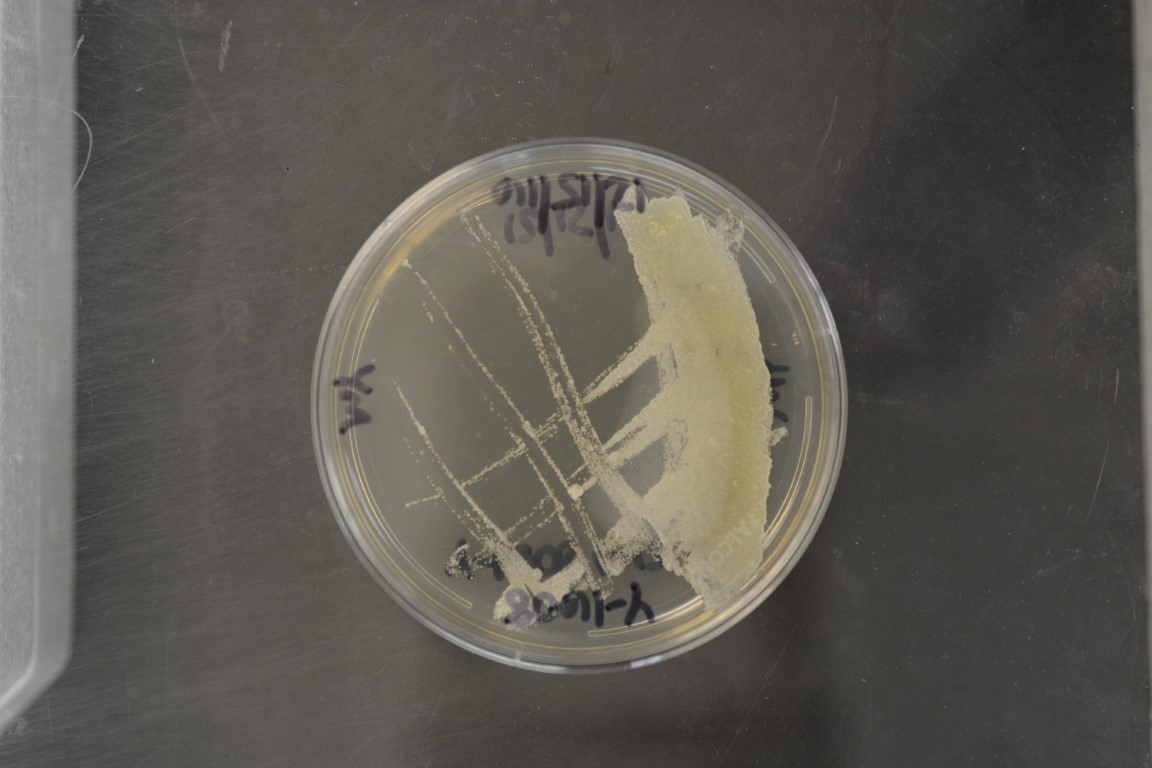

Moniliella mellis
NRRL Y-1608(Type Strain)
Accession numbers in other collections:BKM F-423=CBS 350.33=NBRC 112892=VKM F-423
Source:CBS,Delft,The Netherlands
Isolated from(substrate):FD,honey
Genetic info:GenBank:D1/D2(EU545185).
Growth media:Yeast Extract-Malt Extract-Peptone-Glucose(YM for yeasts)(number 6)
Optimum growth temperature:25C
Strain images:
NRRL_Y-1608_6.JPG